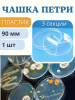
Чашка Петри пластиковая 3 секции D-90 мм
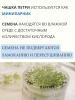
Чашка Петри пластиковая 3 секции D-90 мм

Чашка Петри 90 мм 3-х секционная ПС, стерильные
Чашка Петри 90 мм пластиковая 3х секционная - является одним из самых распространенных видов лабораторной посуды. Широко используется в медицине, незаменима в культивирование микроорганизмов, проращивание семян растений, наблюдение за образцами простым глазом и микроскопом, демонстрации химических опытов. Изготавливаются из нейтрального прозрачного полистирола, что визуально позволяет наблюдать за содержимым.
Чашка Петри пластиковая, стерильная, для многократного использования. Становятся всё более популярными среди садоводов для выращивания микрозелени, проращивания семян для рассады.
Все чаще используется дачниками как минипарник для замачивания и проращивания семян. В емкости можно проращивать одновременно 3 вида семян благодаря трем секциям.
В Чашке Петри семена находятся во влажной среде с достаточным количеством кислорода, не подвергаются ни замоканию, ни пересушиванию.
На дно укладывают в несколько слоев увлажненную фильтровальную бумагу или ватный диск. Использовать ткань не желательно.
При выборке проросших семян могут обломиться кончики вросших в ткань корешков, а из размокшей бумаги корешки легко вынимаются не поврежденными.
На влажную бумагу раскладывают семена, накрывают крышкой и ставят в теплое место, где обеспечивается температура 22-25°С.
Для лучших всходов Чашки Петри можно поместить под фитолампу на время проращивания. проращивать семена любого размера, вплоть до самых мелких.
Посев регулярно проверяют и по мере надобности увлажняют бумагу. Таким способом можно проращивать семена любого размера, вплоть до самых мелких. Мелкие семена (вероники, камнеломки, гипсофилы), набухая, заметно увеличиваются в объеме.
Размер: Высота 15 мм, диаметр дна 89 мм, диаметр крышки 92 мм.
|
Описание
|
Прозрачный лабораторный сосуд в форме невысокого плоского цилиндра, закрываемого прозрачной крышкой |
|
Действие
|
Незаменима в культивирование микроорганизмов, проращивание семян растений, наблюдение за образцами простым глазом и микроскопом, демонстрации химических опытов. Изготавливаются из нейтрального прозрачного полистирола, что визуально позволяет наблюдать за содержимым. Используется дачниками как минипарник для замачивания и проращивания семян. Для лучших всходов Чашки Петри можно поместить под фитолампу на время проращивания. проращивать семена любого размера, вплоть до самых мелких. |
|
Преимущества
|
При замачивании семена находятся во влажной среде с достаточным количеством кислорода, не подвергаются ни замоканию, ни пересушиванию. |
|
Вид
|
Чашка Петри |
|
Параметр: Категория 1
|
Выращивание рассады, саженцев и комнатных растений |
|
Параметр: Категория 2
|
Оборудование для проращивания семян |
.jpeg)


.png)